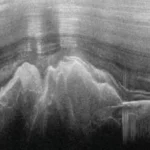
Antarctica's Gamburtsev Mountains covered by ice, discovered using sound waves in 1958.

The India Meteorological Department (IMD) has issued a comprehensive weather forecast highlighting significant weather events expected across the country from May 12-17, 2025. According to DownToEarth, the forecast predicts extremely heavy rainfall in Meghalaya alongside widespread heat wave conditions in multiple regions, creating a complex weather pattern that will affect millions of Indians.
Rainfall Patterns: Northeast India in Focus
Meghalaya faces the most intense precipitation with extremely heavy rainfall predicted at isolated places on May 13, 2025. This event is part of a broader weather system that will bring widespread light to moderate rainfall across Northeast India for the next five days.
The Nicobar Islands will also experience isolated heavy rainfall on May 13-14, while Sub-Himalayan West Bengal and Sikkim will see similar conditions during May 12-15, with very heavy rainfall specifically on May 12.
| Region | Rainfall Prediction | Dates |
|---|---|---|
| Meghalaya | Extremely heavy rainfall in isolated places | May 13, 2025 |
| Northeast India (general) | Widespread light to moderate rainfall | May 12-17, 2025 |
| Nicobar Islands | Isolated heavy rainfall | May 13-14, 2025 |
| Sub-Himalayan West Bengal & Sikkim | Isolated heavy rainfall with very heavy rainfall on May 12 | May 12-15, 2025 |
Heat Wave Conditions: Multiple Regions on Alert
While the northeast experiences heavy rainfall, several regions across northwestern, eastern, central, and southern India will face heat wave conditions during May 12-17. The IMD defines heat waves based on specific temperature thresholds – a maximum of at least 40°C in plains and 30°C in hilly regions. When actual temperatures reach or exceed 45°C in plains, this also meets heat wave criteria.
- Plains regions require temperatures to reach at least 40°C to qualify as a heat wave, making daily activities challenging for residents who must take extra precautions against heat-related illnesses.
- Hilly areas have a lower threshold of 30°C, which may seem moderate to plains dwellers but is unusually warm for mountain communities whose infrastructure isn’t designed for such heat.
- When temperatures hit 45°C or higher in any plains region, this automatically qualifies as a heat wave condition regardless of normal temperature patterns, presenting serious health risks.
- Temperature departures from normal seasonal levels also factor into heat wave classifications, helping meteorologists identify unusual warming patterns even when absolute temperatures aren’t extreme.
Regional Weather Breakdown: Thunderstorms and Gusty Winds
The weather systems will be accompanied by thunderstorms, lightning, and gusty winds with speeds ranging from 30-60 kilometers per hour. These conditions will affect Bihar, Gangetic West Bengal, Jharkhand, North Coastal Odisha, Uttar Pradesh, Rajasthan, Madhya Maharashtra, Konkan & Goa, Gujarat, Madhya Pradesh, Chhattisgarh, Tamil Nadu, Puducherry, Karaikal, Rayalaseema, and the Andaman & Nicobar Islands.
Gusty winds – sudden strong bursts of wind that can reach high speeds quickly – pose risks to structures, vegetation, and outdoor activities. When combined with thunderstorms and lightning, these weather events require residents to stay alert and take appropriate safety measures.
Looking Forward
These weather patterns reflect seasonal changes and meteorological conditions typical for this time of year, though the extreme nature of some events warrants special attention. The IMD continues to monitor these developments and will provide updates as conditions evolve.